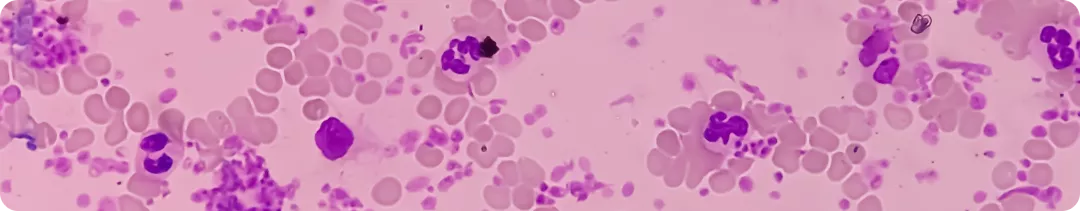
Определение, распространенность и клиническая картина эссенциальной тромбоцитемии

Image
Определение, распространенность и клиническая картина эссенциальной тромбоцитемии
Эссенциальная тромбоцитемия (ЭТ) — это миелопролиферативное заболевание (МПЗ), которое характеризуется неконтролируемой пролиферацией мегакариоцитов, повышенным количеством крупных и гигантских мегакариоцитов в костном мозге, тромбоцитозом в периферической крови (более 450 × 109/л), высоким риском как тромбозов, так и кровотечений1–3.
Популяционные эпидемиологические данные о заболеваемости и распространенности МПЗ в России отсутствуют. При анализе 10-летней динамики заболеваемости в Санкт-Петербурге первичная заболеваемость ЭТ составляет 0,6–2,1 (среднее — 1,3) случаев на 100 тыс. населения1.
Клиническая картина
Клиническая картина эссенциальной тромбоцитемии (ЭТ) включает следующие проявления1–3:
- симптомы общего характера (утомляемость, снижение концентрации внимания);
- эритромелалгия (болезненные покраснения в области пальцев рук и ног, отек и жжение);
- нарушения микроциркуляции головного мозга (транзиторные ишемические атаки), которые представляют собой периодические проходящие нарушения зрения, речи (дизартрия) или походки, головные боли, нарушение ясности сознания, головокружения или мигрени;
- тромбозы венозной и эмболы артериальной систем;
- кровотечения;
- высокая частота спонтанных невынашиваний беременности, плацентарных инфарктов с последующим нарушением роста и гибелью плода.
Список литературы
- Меликян А.Л., Суборцева И.Н., Ковригина А.М. и др. Национальные клинические рекомендации по диагностике и лечению Ph-негативных миелопролиферативных заболеваний (истинной полицитемии, эссенциальной тромбоцитемии, первичного миелофиброза) (редакция 2024 г.). Клиническая онкогематология. 2024;17(3):291–334. doi: 10.21320/2500-2139-2024-17-3-291-334.
- Arber D. A., Orazi A., Hasserjian R. et al. The 2016 revision to the World Health Organization classification of myeloid neoplasms and acute leukemia. Blood 2016; 127:2391—2405; doi: https://doi.org/10.1182/blood-2016-03-643544
- Воробьев А. И. Руководство по гематологии. — М.: Ньюдиамед, 2003; стр. 9—15.
732635/JAK/webpage/10.23/0